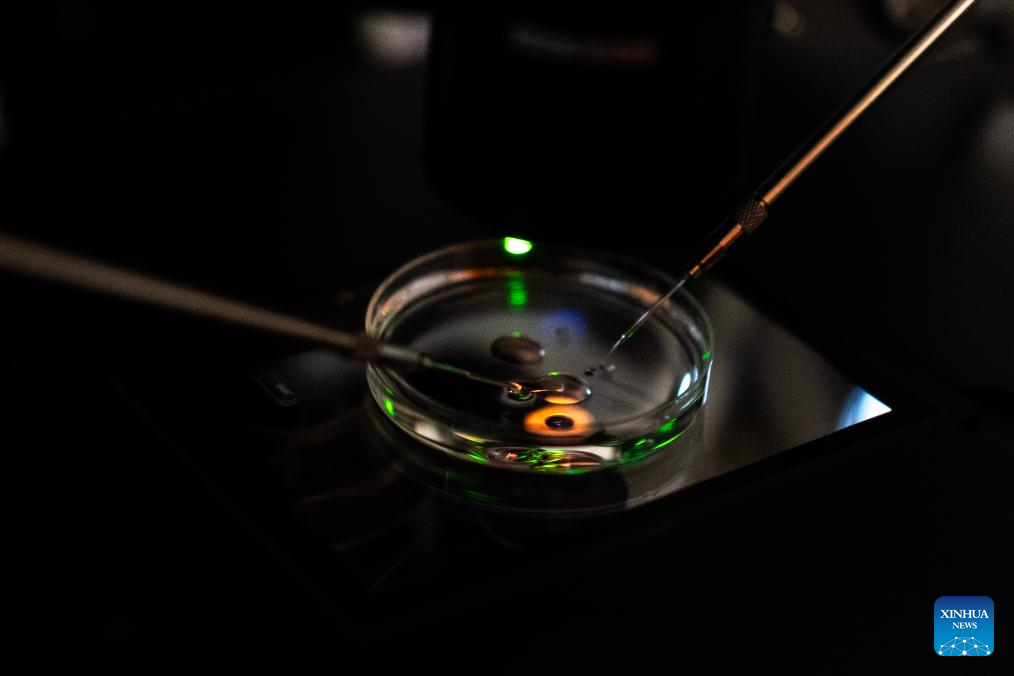

SAN ANTONIO DE ARECO, 2 mayo, 2025 (Xinhua) -- Imagen del 28 de abril de 2025 de la médica veterinaria Lucía Lupacchini (i) controlando ejemplares equinos clonados y editados genéticamente junto a una yegua portadora o receptora (2-i) en el sector de neonatología de la empresa argentina Kheiron Biotech en un campo, en la ciudad de San Antonio de Areco, Argentina. La clonación y la edición genómica amplían las fronteras del potencial deportivo de ejemplares equinos en Argentina, lo que no solo impulsa mejoras generacionales de caballos vinculados a ámbitos como el polo, sino que también potencia las exportaciones del sector biotecnológico del país, según expertos en la materia. (Xinhua/Martín Zabala)
BUENOS AIRES, 2 may (Xinhua) -- La clonación y la edición genómica amplían las fronteras del potencial deportivo de ejemplares equinos en Argentina, lo que no solo impulsa mejoras generacionales de caballos vinculados a ámbitos como el polo, sino que también potencia las exportaciones del sector biotecnológico del país, según expertos en la materia.
El sector genera más de 30 millones de dólares anuales en concepto de exportaciones, de acuerdo con datos de la Cámara de la Industria Nacional Equina de 2024.
A su vez, el impacto económico del polo y el "turf" (carreras con apuestas) combinados alcanzaría los 500 millones de dólares al año, según estimaciones de la Asociación Argentina de Polo.
En este marco cobra mayor relevancia la labor científica de expertos argentinos en biotecnología, que a partir de la clonación y la modificación genética han mejorado las capacidades físicas de los caballos de polo, una práctica deportiva en que la velocidad y la fuerza de los animales resultan factores clave.
A la cabeza de estos desarrollos se encuentra la empresa argentina Kheiron Biotech, cuyo cofundador y director científico, Gabriel Vichera, explicó en entrevista reciente con Xinhua el trabajo que llevan a cabo, así como sus ventajas y perspectivas.
"Nuestro principal servicio es la clonación de caballos de élite deportiva", explicó Vichera durante la entrevista en las instalaciones que la compañía posee en la localidad de Pilar, 60 kilómetros al norte de Buenos Aires, la capital del país austral.
"Nosotros comenzamos comercialmente en el 2012. En el año 2013, ya obtuvimos el primer clon de una yegua generada en el país, y durante todos estos años venimos brindando este servicio de clonación y a su vez poniendo mucho énfasis en la investigación", completó.
Vichera recordó que Argentina es el principal productor mundial de caballos de polo en la categoría de élite deportiva, así que la biotecnología aplicada permite "resguardar" este "background genético" o experiencia genética y que no se pierda en las generaciones.
Investigadores argentinos han sido capaces de traer de regreso a animales que murieron hace más de 20 años, al estimarse que el país sudamericano consiguió unos 2.000 clones gestados a nivel local en 2024, además de las crías que nacieron de esas réplicas.
"Uno con la clonación puede volver a la vida de animales que fueron 'supercracks' en otras décadas y volviendo a la vida esos animales podemos generar cruzas con animales actuales, que de otra forma en la naturaleza no podría darse", explicó el investigador.
La tarea de los expertos incluye el aporte de biólogos, biotecnólogos, veterinarios, genetistas y agrónomos que desarrollan tareas en Pilar, así como en campos ubicados en San Antonio de Areco, unos 110 kilómetros al noroeste de la capital argentina, donde términos como polo, caballos o equitación son vocablos habituales.
"Acá en Argentina, los torneos más importantes de polo se dan durante la primavera (austral), que coincide con el período reproductivo de las yeguas", comentó Vichera.
"Entonces, si tengo una yegua importante que está jugando, tengo que esperar que terminen estos torneos y tratar de generar embriones en verano, que no es lo óptimo. Si yo tengo réplicas, si tengo copias, puedo tener algunas jugando y otras en los procedimientos reproductivos para obtener crías. Esas son algunas de las principales ventajas que tiene la clonación", consideró.
Los investigadores han desarrollado también tratamientos de "stem cells" (células madre), una tecnología que se utiliza para tratar condiciones crónicas en los animales como la artritis o lesiones de tendón, ligamento y fracturas que no hayan respondido a terapias convencionales.
Han logrado, además, la edición genética a partir de la utilización de una herramienta biotecnológica conocida como CRISPR/Cas o "tijeras moleculares" para modificar el ácido desoxirribonucleico (ADN).
Vichera detalló que se trata de una tecnología innovadora que permite la edición de genes de manera precisa con pequeños ajustes en el genoma de los animales de manera segura.
El experto subrayó que la utilización de técnicas propias de edición genómica en combinación con la clonación permite adquirir rasgos o características genéticas en una única generación y de forma no azarosa.
"Generamos a fin del año pasado los primeros caballos de diseño genético del mundo ¿Esto qué significa? Que nosotros diseñamos su genoma previamente a que nazcan esos animales", describió el entrevistado.
"¿Y cómo se realiza este procedimiento? Utilizando las tecnologías denominadas de 'tijeras genéticas', la tecnología CRISPR/Cas9 que nos permite en un cultivo celular del animal donante que uno quiere clonar, reescribirle el genoma y agregarle alguna característica diferente a la que ya viene con ese animal, previamente al procedimiento de clonación", complementó.
A decir de Vichera, este procedimiento representa "una gran ventaja", pues ayuda al progreso genético tanto de la especie equina como de otras.
Dijo que los principales interesados en los desarrollos tecnológicos de la compañía se encuentran en Argentina y son criadores de caballos de polo o jugadores de ese deporte.
Remarcó que la tecnología de clonación permite además la producción de clones de ejemplares de "endurance" (resistencia en largas distancias) o bien de salto y "dressage" (doma clásica), lo que genera a su vez la atención de personas de otros países y regiones del mundo.
"Las perspectivas a futuro es seguir creciendo. Desde nuestros comienzos hace más de una década, año a año vamos creciendo en el número de clones que generamos, en el número de nuevos clientes", dijo el entrevistado.
"Hemos desarrollado los primeros equinos del mundo de diseño genético (...) y siempre que encontremos una tecnología de vanguardia que pueda servir para los criadores, los productores, ahí estamos presentes nosotros", completó Vichera.

SAN ANTONIO DE ARECO, 2 mayo, 2025 (Xinhua) -- Imagen del 28 de abril de 2025 de un ejemplar equino clonado y editado genéticamente en el sector de neonatología de la empresa argentina Kheiron Biotech en un campo, en la ciudad de San Antonio de Areco, Argentina. La clonación y la edición genómica amplían las fronteras del potencial deportivo de ejemplares equinos en Argentina, lo que no solo impulsa mejoras generacionales de caballos vinculados a ámbitos como el polo, sino que también potencia las exportaciones del sector biotecnológico del país, según expertos en la materia. (Xinhua/Martín Zabala)

SAN ANTONIO DE ARECO, 2 mayo, 2025 (Xinhua) -- Vista aérea tomada con un dron el 28 de abril de 2025 de ejemplares equinos clonados en el sector de neonatología de la empresa argentina Kheiron Biotech en un campo, en la ciudad de San Antonio de Areco, Argentina. La clonación y la edición genómica amplían las fronteras del potencial deportivo de ejemplares equinos en Argentina, lo que no solo impulsa mejoras generacionales de caballos vinculados a ámbitos como el polo, sino que también potencia las exportaciones del sector biotecnológico del país, según expertos en la materia. (Xinhua/Ezequiel Putruele)

PILAR, 2 mayo, 2025 (Xinhua) -- Imagen del 24 de abril de 2025 de la biotecnóloga Emilia Batista (i) y la veterinaria Florencia Iriarte (d) preparando medios de cultivo en una cabina de flujo laminar en el laboratorio de embriología de la empresa argentina Kheiron Biotech, en la ciudad de Pilar, Argentina. La clonación y la edición genómica amplían las fronteras del potencial deportivo de ejemplares equinos en Argentina, lo que no solo impulsa mejoras generacionales de caballos vinculados a ámbitos como el polo, sino que también potencia las exportaciones del sector biotecnológico del país, según expertos en la materia. (Xinhua/Martín Zabala)

PILAR, 2 mayo, 2025 (Xinhua) -- Imagen del 24 de abril de 2025 de miembros del equipo científico laborando en el laboratorio de embriología de la empresa argentina Kheiron Biotech, en la ciudad de Pilar, Argentina. La clonación y la edición genómica amplían las fronteras del potencial deportivo de ejemplares equinos en Argentina, lo que no solo impulsa mejoras generacionales de caballos vinculados a ámbitos como el polo, sino que también potencia las exportaciones del sector biotecnológico del país, según expertos en la materia. (Xinhua/Martín Zabala)

PILAR, 2 mayo, 2025 (Xinhua) -- Imagen del 24 de abril de 2025 de la veterinaria Florencia Iriarte preparando medios de cultivo en una cabina de flujo laminar en el laboratorio de embriología de la empresa argentina Kheiron Biotech, en la ciudad de Pilar, Argentina. La clonación y la edición genómica amplían las fronteras del potencial deportivo de ejemplares equinos en Argentina, lo que no solo impulsa mejoras generacionales de caballos vinculados a ámbitos como el polo, sino que también potencia las exportaciones del sector biotecnológico del país, según expertos en la materia. (Xinhua/Martín Zabala)

PILAR, 2 mayo, 2025 (Xinhua) -- Imagen del 24 de abril de 2025 del cofundador y director científico de la empresa Kheiron Biotech, Gabriel Vichera (frente), y la bióloga Mariana Suvá (atrás) realizando una enucleación de ovocitos en microscopios con sistema de micromanipulación en el laboratorio de embriología de la empresa argentina Kheiron Biotech, en la ciudad de Pilar, Argentina. La clonación y la edición genómica amplían las fronteras del potencial deportivo de ejemplares equinos en Argentina, lo que no solo impulsa mejoras generacionales de caballos vinculados a ámbitos como el polo, sino que también potencia las exportaciones del sector biotecnológico del país, según expertos en la materia. (Xinhua/Martín Zabala)
PILAR, 2 mayo, 2025 (Xinhua) -- Imagen del 24 de abril de 2025 de la bióloga Mariana Suvá realizando una enucleación del ovocito en un microscopio con sistema de micromanipulación en el laboratorio de embriología de la empresa argentina Kheiron Biotech, en la ciudad de Pilar, Argentina. La clonación y la edición genómica amplían las fronteras del potencial deportivo de ejemplares equinos en Argentina, lo que no solo impulsa mejoras generacionales de caballos vinculados a ámbitos como el polo, sino que también potencia las exportaciones del sector biotecnológico del país, según expertos en la materia. (Xinhua/Martín Zabala)

PILAR, 2 mayo, 2025 (Xinhua) -- Imagen del 24 de abril de 2025 de la veterinaria embrióloga Elisabet Wiedenmann manipulando muestras conservadas en un tanque de nitrógeno líquido en el laboratorio de embriología de la empresa argentina Kheiron Biotech, en la ciudad de Pilar, Argentina. La clonación y la edición genómica amplían las fronteras del potencial deportivo de ejemplares equinos en Argentina, lo que no solo impulsa mejoras generacionales de caballos vinculados a ámbitos como el polo, sino que también potencia las exportaciones del sector biotecnológico del país, según expertos en la materia. (Xinhua/Martín Zabala)

PILAR, 2 mayo, 2025 (Xinhua) -- Imagen del 24 de abril de 2025 del biólogo molecular Juan Ignacio Bastón cambiando de medio a cultivos de biopsias de dermis en una cabina de flujo laminar en el laboratorio de embriología de la empresa argentina Kheiron Biotech, en la ciudad de Pilar, Argentina. La clonación y la edición genómica amplían las fronteras del potencial deportivo de ejemplares equinos en Argentina, lo que no solo impulsa mejoras generacionales de caballos vinculados a ámbitos como el polo, sino que también potencia las exportaciones del sector biotecnológico del país, según expertos en la materia. (Xinhua/Martín Zabala)








